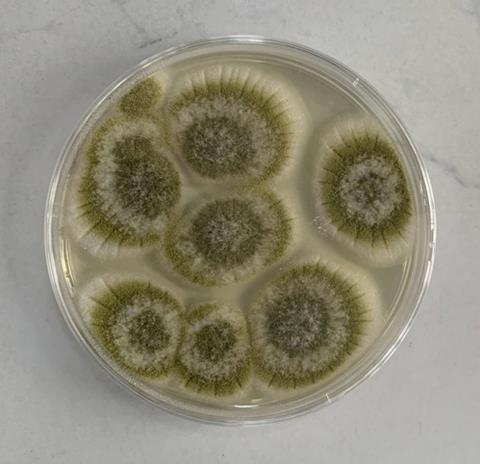
plat11

Taiwo Boluwatife Omowunmi reports back on her AMI-sponsored summer studentship which assessed native microbial strains for mycotoxin biocontrol in stored nuts.
Taiwo (22), from Ogun State, Nigeria, is a microbiology undergraduate at Federal University of Agriculture, Abeokuta. She I carried out her placement in Dr Oni Eniola’s laboratory in the Department of Microbiology working directly with Dr. Oni and members of her research team.

The placement was focused on isolation and characterization of native microbial strains and evaluating their antifungal potential as biocontrol agents to reduce mycotoxin contamination in stored groundnuts and cashew nuts.
My hands-on activities included: collecting and processing nut samples (from retailers and stores); isolating fungal strains from stored nuts; performing morphological and basic characterization; setting up antagonism assays (e.g., dual culture/inhibition assays) to screen isolates for antifungal activity; and participating in preliminary storage trials to observe effects on fungal growth. I also helped with data recording, preparing culture media, and basic result interpretation.
Real-world aims
The lab’s broader goal is to develop safe, affordable, and locally-adapted biocontrol solutions that reduce fungal growth and mycotoxin production in staple nuts — improving food safety, preventing health risks, and reducing post-harvest losses for farmers and traders.
My project contributes by identifying native strains that can be further developed into biological treatments or storage-management tools that are culturally and economically appropriate for Nigerian smallholders.
We identified several promising antagonistic isolates - fungal (Trichoderma-like) strains and several Aspergillus that noticeably inhibited growth of common mycotoxigenic fungi in our in-vitro assays.
What surprised me most was how effective some locally sourced isolates showed rapid inhibition in dual culture tests and performed consistently across multiple nut samples. I was also pleasantly surprised by how much practical laboratory skill I gained in a short time, from sterile technique to designing simple inhibition assays.
Cost-effective biocontrol
These findings suggest that locally sourced microbes could become cost-effective biocontrol agents, offering farmers and storage operators an alternative to chemical fungicides. Reducing mycotoxin contamination improves consumer health, preserves the value of harvests (better marketability and export potential), and lowers economic losses. In short — it’s a practical step toward safer nuts on the plate and more secure incomes for producers in Nigeria and globally.

The next steps include: molecular identification of the best isolates (to species level), quantitative mycotoxin assays on treated versus control kernels (ELISA or similar where available), optimizing application methods for smallholder contexts, and designing longer-term storage trials.
I also plan to help prepare a short manuscript for publication with the Journal of Food Safety and Hygiene and also make a poster and share results with local stakeholders and farmer groups, and to apply for follow-up funding to scale the most promising fungal candidates.
Least favourite job in the lab? Without a doubt; washing and rinsing petri dishes and glassware after a long day of plating. It’s humble but absolutely essential!

I am deeply grateful to the AMI Summer Student Grant 2025 and to my supervisor, Dr (Mrs) Oni Eniola, for this opportunity. The seven weeks provided invaluable practical experience and a clear path forward for turning promising isolates into solutions that matter to communities and markets alike.
Find out more about AMI’s grants.







No comments yet